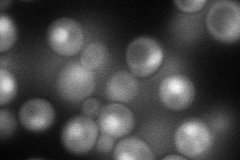
YPL213W
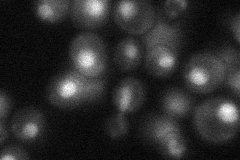
YPL213W
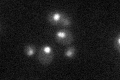
YPL213W

View description
Component of U2 snRNP; disruption causes reduced U2 snRNP levels; physically interacts with Msl1p; invovled in telomere maintenance; putative homolog of human U2A' snRNP protein
Localization:
Intensity:
Fold change:
Significance:
-
C’ GFP library in SD

nucleus28.15 -
N' NOP1pr-GFP in SD
cytosol,nucleus85.748 -
N' TEF2pr-mCherry in SD

nucleus89.9071 -
N' NATIVEpr-GFP in SD
nucleus33.8599 -
N' TEF2pr-VC and Cyto-VN in SD

nucleus38.8871 -
C’ GFP library in SD+DTT

nucleus31.771.12No -
C’ GFP library in SD+H2O2

nucleus17.90.63Yes -
C’ GFP library in Starvation Media
nucleus41.141.46Yes -
C’ GFP library on the background of Pup2-DaMP

nucleus -
C’ GFP library on the background of CCT mutant

nucleus27.30940.969876No
